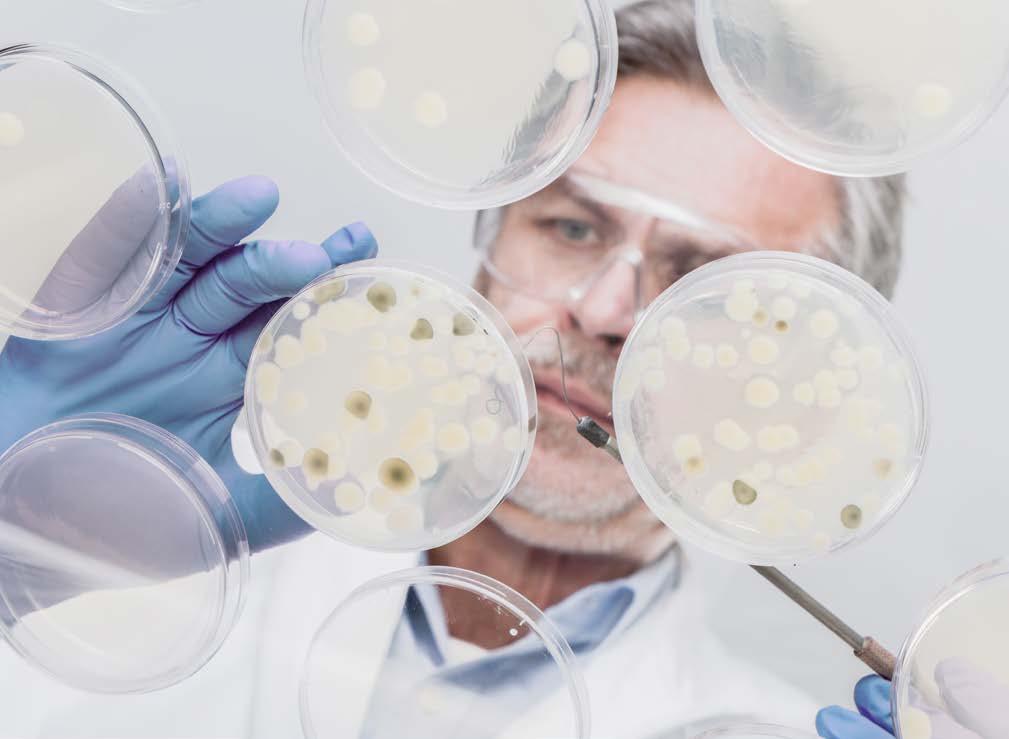

External Advisory Board Meeting




Summary
The NIHR Exeter Biomedical Research Centre (BRC) is a partnership between the University of Exeter and Royal Devon University Healthcare NHS Foundation Trust, working with NHS partners across the South West to deliver experimental medicine and early translational research that improves patient care. Funded between 2022 and 2028, the BRC brings together internationally competitive discovery science, strong clinical integration, embedded patient and public involvement, and growing commercial engagement across five research themes.
With sustained institutional investment, robust governance and shared infrastructure, Exeter BRC is demonstrating strong progress in translation, innovation and workforce development, with a particular focus on addressing the needs of ageing, rural and coastal populations, and delivering research with national and international impact. The NIHR agrees objectives with the BRC and has a system of quarterly and annual monitoring to track and review progress.
This report presents progress against these objectives and provides additional data, self-appraisal and a forward look to the next BRC competition.
Further information about our research, partnerships and impact is available on the NIHR Exeter Biomedical Research Centre website www.exeterbrc.nihr.ac.uk
Figure 1. Geography of the NIHR Exeter Biomedical Research Centre. The map shows the locations of the University of Exeter’s main campuses and the NHS partner organisations, illustrating the BRC’s distributed presence across the South West and its reach into urban, rural and coastal communities.
St George’s University Hospitals NHS Foundation Trust
Royal Devon University Healthcare NHS Foundation Trust - Northern Somerset NHS Foundation Trust
Royal Devon University Healthcare NHS Foundation Trust, Devon Partnership NHS Trust, University of Exeter - Streatham and St Luke’s Campuses
University of Exeter Penryn Campus
Royal Cornwall Hospitals NHS Trust and University of Exeter Truro Campus
Cornwall Partnership NHS Foundation Trust
1. Introduction
1.1 Foreword
On behalf of all partners of the Exeter NIHR Biomedical Research Centre, we are delighted to share our work, highlighting the progress we have made over the past three years to translate scientific discoveries into better health and care for patients. Our BRC research spans five themes: Clinical Mycology, Rehabilitation, Diabetes, Genetics & Genomics, and Neurodegeneration, each bringing internationally recognised expertise and strong partnerships to address major health challenges. Our achievements reflect the dedication of our research and clinical workforce, our trainees, our public contributors, and the patient representatives and many participants who shape our BRC and take part in our studies. Through close collaboration across the NIHR infrastructure, industry, and our regional health system, we continue to accelerate translational research, drive excellence in experimental medicine, and improve outcomes for people across our region, the UK and beyond.
Thank you to everyone who has contributed to our mission. Together, we are strengthening research in our region and delivering meaningful change for patients and communities.


A snapshot of our research impact
582 Projects supported
14,852
Participants recruited, powering clinical studies
£154 million
Leveraged in external research funding
250
Researchers trained in Patient and Public Involvement and Engagement (PPIE)
Professor Sallie Lamb Director, NIHR Exeter Biomedical Research Centre.
Professor Helen Quinn Research and Development Director, Royal Devon University Hospital.
1.2 NIHR Exeter BRC at a glance
NIHR Biomedical Research Centres (BRCs) are partnerships between leading universities and NHS organisations. They focus on experimental medicine and early-stage research, developing new treatments, diagnostics and health technologies.
Backed by nearly £800 million of NIHR investment across England, 20 BRCs provide the expertise, facilities and collaborative environment needed for translational research to thrive. Their work involves outstanding scientists and clinicians, delivers world-leading research, and draws significant additional investment from charities, industry and international funders, supporting economic growth while improving lives.
Prior to the 2020 BRC competition, there had been no new Biomedical Research Centre for over 20 years. In December 2022, Exeter joined this elite group of NHS/Universities partnerships. The award made was ~£16 million, over a fiveyear period.
The BRC current research themes, shown in figure 3, were selected based on world-leading excellence in discovery science and clear evidence of translation into patient benefit and/or effective commercial collaboration, alongside four emerging areas of excellence identified to support future growth.
1.3 Contextual information - foundations of the BRC
Since the 1980s, the university working in partnership with the Royal Devon University Healthcare NHS Foundation Trust (RDUH), established strengths in Diabetes and Genetics and Genomics to deliver nationally significant genomic services for the NHS and a shared culture of rapid translation from discovery to clinical practice. The partnership also has a long history of surgical innovation, including the development of the Exeter Hip Stem, one of the world’s most widely used hip replacement implants.
The university has made sustained and strategic investment in STEM-Medicine, including relocation of the MRC Centre for Medical Mycology (£8m) from Aberdeen (2019), establishment of the Living Systems Institute (£60+m, 2014), targeted investment in neuroscience (£8m, 2020), and major expansion of diabetes research capacity through UKRI Expanding Excellence in England funding (£6.6m plus £7m University match, 2019). Further investment and philanthropy have strengthened programmes in dementia and rehabilitation (2019 onward), alongside recent university-wide investments in computer science and engineering (2024). At the same time, RDUH had been investing in clinical academic research groupings, building capacity in clinical research in Diabetes, Genetics and Genomics and Surgery (amongst others).
The RDUH and University have developed joint R&D spaces, including the RILD buildings in Exeter, where NHS and university researchers work alongside and with each other. This space houses genomic and sample laboratories, state-of-the-art-sequencers, a Clinical Research Facility and Commercial Research Centre. More recently, our partnership secured £7.5 million through the NIHR Capital Investment funding call — a scheme open to NHS organisations in England to strengthen research infrastructure — enabling us to develop new facilities, including a modular research centre in North Devon, mobile patient research vans, and a technology centre in Exeter to improve research capacity and access.
1.4 University of Exeter
University of Exeter (UoE) received its Charter as a University in 1955. It is a small university with about 36,000 students and two main sites (Exeter and Truro/ Penryn in Cornwall). Exeter is a partner in the GW4 collaboration with the Universities of Bath, Bristol, and Cardiff.
1.5 Royal Devon University Healthcare NHS Foundation Trust (RDUH)
Royal Devon University Healthcare NHS Foundation Trust (RDUH) is the lead NHS partner and host for the Exeter BRC, serving over 615,000 people across Devon through two acute hospitals (one in North Devon, the other in Exeter) and an extensive community hospital network. RDUH hosts multiple NIHR infrastructures for the South West, including the HealthTech Research Centre, Applied Research Collaboration, Regional Research Delivery Network and Clinical Research Facility.
1.6 Other NHS partners
In addition to RDUH, the Exeter BRC partners with Somerset NHS Foundation Trust, Devon Partnership NHS Trust, Cornwall Partnership NHS Foundation Trust, Royal Cornwall Hospitals NHS Trust and St George’s University Hospitals NHS Foundation Trust, reflecting a broader NHS partnership footprint than most BRCs. The BRC has delivered significant opportunities for us to develop translational research infrastructure and capacity with our broader family of NHS partners.
1.7 Governance and infrastructure
Oversight is provided by the Joint Strategic Partnership Board, co-chaired by the Chief Executive of RDUH and the Vice-Chancellor of the University of Exeter, with responsibility for strategy, governance and financial oversight of all our activities, including the BRC. In line with NIHR policy, the BRC Director retains overall budgetary responsibility.
Collaboration is supported through a Joint Research Office (JRO), working alongside the RDUH Innovation Hub and Exeter Innovation to enable translation into practice. We continue to strengthen this joint infrastructure improving integration, efficiency and value for money across research and innovation support.
2. Overview of Progress Against Major BRC Objectives
NIHR Investment in the Exeter BRC: Overview
BRC investment has been structured around the themes and focused across four core areas: academic career development for translational medicine; pump-priming projects, providing funding to obtain preliminary data to underpin external grant applications; technical and specialist support services; and core BRC functions. Investment has been broadly balanced across themes and delivered primarily through light-touch internal competitions, with funding advertised openly and peer-reviewed, including public contributor input.
Fellows appointed
Pump-priming projects funded
2.1 Progress against NIHR Exeter BRC overarching objectives (2022–present)
The NIHR agrees short, medium and long-term objectives for the BRC, which are monitored on an annual basis. In addition, the BRC reports quarterly on supported studies, including participantrecruitment data, and submits impact case stories. Objectives are set at an overarching level (Appendix 1), for individual themes (Appendices 2a-2e), and across core areas, including Academic Career Development, Research Inclusion, and Patient and Public Involvement and Engagement (PPIE) (Appendices 3-5).
In the application, 12 overarching objectives were identified (Appendix 1). All are on track, with 5 now completed.
Objectives included establishing the structure, the shared identity and the functions of our newly formed BRC. There are also objectives related to overarching performance, with key metrics to ensure we are making progress as intended. Some of these are longer term objectives, and we report progress to date.
We launched the BRC in Devon, Cornwall and Somerset. We designed fellowship programmes to support senior NHS clinical academic colleagues (BRC Senior Investigator Fellowships); Mid-Career Clinical Fellowships and Translational Fellowships (described in Academic Career Development), and a series of PhD studentships, internships and other opportunities to attract a diversity of people into translational research careers. All but one internal funding round has been commissioned. It is early days to determine if the outcomes of these investments have been successful, but the evidence is encouraging.
We specified leveraged income, commercial income, number of clinical trials, number of externally funded studies, PhD student completion, and success in external fellowship rounds as key metrics of overarching success.
Leveraged External Research income by funder type, 2022-2025
Since 2022, Exeter BRC has doubled leveraged income and secured more than £154m.
Table 1 shows funding by source, categorised as per NIHR reporting criteria outlined in Appendix 1A.
2.3 Patient & Public Involvement and Engagement Strategy
Patients and the public are central to the Exeter BRC’s work, shaping research to ensure relevance and impact. Delivered jointly with the NIHR Exeter Clinical Research Facility, the PPIE strategy embeds involvement across the research lifecycle, builds researcher capability, and widens inclusion across the South West.
patient-facing application. BRC’s innovation pipeline includes 5 active patents, 2 commercial licences and 1 spin-out, with 7 further spin-outs or licences in development, alongside £6.8m in industry research income (2024/25) and 86 active industry partnerships, reflecting growing commercial impact and confidence in the Exeter research environment.
Commercial and non-commercial clinical trials
Collecting data on clinical trials activity has proven challenging, and this will be presented at the board meeting.
2.2 Training and professional development
Our key metrics were to support at least 15 PhD studentships to completion and enable fellowship holders to successfully leverage onward funding. Onward funding success is regularly monitored as outlined in Appendix 11. By leveraging additional philanthropic income, we have recruited 21 BRC
funded PhD students and the first two cohorts have all passed the upgrade stage. We also specified that one quarter of our Senior Investigator Fellowships would be awarded to leading nurses, Allied/Other Health Professionals and this has been achieved.
2.4 Increase commercial engagement
Innovation and commercialisation are central to Exeter BRC’s mission to translate discovery science into improved health outcomes. Working across NHS trusts, the University of Exeter and industry partners, the BRC has developed a translational ecosystem that accelerates research from early-stage discovery to
Major BRC Objectives Summary
We believe we have made strong progress against the overarching objectives, and that importantly, these have delivered a cohesive BRC structure and culture. There are many additional benefits not captured by the objectives. The BRC has been a stimulus to much better working between the University and its NHS partners and turning the focus out into our broad region. We have been able to nurture new themes and establish ourselves as a collaborative member of the BRC national family actively participating in important national agenda such as the Mental Health Mission, Dementia Mission and Translational Research Collaboratives. We have stepped into lead important national infrastructure in Functional Genomics, and in support of Genomic England and worked actively overseas in a way that delivers important benefits to the diverse population of the UK.
Table 1. Leveraged External Research Income by Funder Type, 2022–2025
Figure 5. Professional Composition of NIHR Exeter BRC Funded Fellowships, PhD students, pre-applications awardees, interns and PTY students.
3. Progress Across BRC Research Themes
The Exeter Biomedical Research Centre delivers its research through five inter-connected themes. In the sections that follow, each theme is presented using a consistent structure, outlining the clinical and scientific context, strategic research focus, methods and approaches, 10 most important publications, and forward priorities.
Theme-specific objectives, agreed with NIHR, are provided in Appendix 2a-2e, alongside detailed performance metrics and outputs.
All impact case studies submitted to NIHR arising from themes’ work are listed in Appendix 12. These include evidence of direct translation to patient benefit.
3.1 Clinical Mycology
3.2 Diabetes
3.3 Genetics and Genomics
3.4 Neurodegeneration
3.5 Rehabilitation


3.1 Clinical Mycology
1. Introduction
The impact of fungal infections on human morbidity and mortality is immense, killing 1.5m people every year, yet remaining critically understudied. Effective management of fungal infections is hugely challenged by diagnostic difficulties, limited therapeutic options and emerging antifungal resistance. There are no vaccines or established immunotherapies. Consequently, there is an urgent need for more research in this field to improve patient outcomes. The WHO has highlighted those challenges in two recently published reports entitled ‘The Fungal Pathogen Priorities List’ and ‘Antifungal agents in clinical and preclinical development: overview and analysis’.
The clinical mycology theme is a highly successful group at the intersection of biosciences and translational medicine, focused on understanding fungal pathogenesis, host immunity and on improving the diagnosis, prevention and treatment of fungal diseases. Embedded within the MRC Centre for Medical Mycology, one of the largest medical mycology groupings worldwide, scientific discoveries are being translated into clinical practice and global guidelines that improve care for serious fungal infections across the world.
Three main research areas were specified in the application:
i. Understanding patient susceptibility to provide personalized and targeted management strategies with improved outcomes.
ii. Defining Aspergillus disease phenotypes in patients with chronic lung disorders to allow for biomarker identification enabling stratified medicine.
iii. Developing novel management strategies to reduce the impact and development of antifungal resistance and improve patient outcomes.
Impact case studies submitted to NIHR as part of the original application:
i. Improving the outcome of cryptococcal meningitis
ii. Novel fungal diagnostics
iii. Novel immunotherapy for chromoblastomycosis
Methods: Discovery science and integration of clinical, biomarker, and genetic data, alongside translational studies.
Objectives: Eight, 5 green 2 amber 1 red (now modified).
2. Top 10 publications
1. Plumpton EL et al. (2025). Activation status of airway immune cells is a defining feature of severe asthma. Mucosal Immunology.
2. Ellis J et al. (2025). EBV and CMV co-infection and mortality risk in HIV-associated cryptococcal meningitis. The Lancet HIV.
3. Townsend K et al. (2025). IL-17 deficiency as a susceptibility factor in cryptococcosis. Clinical & Experimental Immunology.
4. Tsai DHT et al. (2025). Burden of neonatal invasive candidiasis in LMICs: systematic review and meta-analysis. Open Forum Infectious Diseases.
5. Inman R et al. (2025). Pan-fungal screening platform for antifungal drug discovery. Antimicrobial Agents and Chemotherapy.
6. Nev OA et al. (2024). Metabolic modelling to identify Pneumocystis growth medium components PLoS Computational Biology.
7. Hudson AC et al. (2024). Spatio-temporal localisation of a pan-Mucorales antigen. Journal of Infectious Diseases.
8. Malamud M et al. (2024). Recognition and control of neutrophil extracellular trap formation by MICL. Nature.
9. Brown GD et al. (2024). The pathobiology of human fungal infections. Nature Reviews Microbiology.
10. Roselletti E et al. (2023). Zinc prevents vaginal candidiasis by inhibiting inflammatory fungal protein expression. Science Translational Medicine.
3. Funding
4. Forward Look
Key areas for the future
Antifungal Drug Discovery and Novel Treatment Approaches: Identify and develop novel compounds with antifungal activity through partnerships with the Dundee Drug Discovery Unit and commercial collaborators. Evaluate new preventive and treatment approaches to address life-threatening invasive fungal infections, with a focus on emerging antifungal resistance.
Mitigating Antifungal Resistance: Develop strategies to reduce the consequences of resistance, including optimising therapeutic regimens, understanding heteroresistance, and implementing combination therapies. Generate data to inform stewardship policies and improve patient outcomes.
5. Success Stories
The MRC CMM Partnership Summit, the world’s first summit bringing commercial and academic partners togethers, in collaboration with the NIHR Exeter BRC, brought 33 companies, 7 funders and 47 academics together. The summit has been highly successful in fostering formal commercial collaborations, explorative discussions about partnerships and advancing translational mycology research.
The MRC CMM delivered jointly with other partners a global training programme in Cape Town, bringing together clinicians and laboratory technicians to strengthen the diagnosis and management of deadly fungal infections. By equipping health professionals across Africa and Asia with practical skills, the
Novel Diagnostics and Clinical Management: Advance point-of-care and laboratory diagnostic tools through collaborations with commercial partners. Integrate novel diagnostics into clinical workflows to improve early detection and management of fungal infections in high-risk populations.
Translational Insights into High-Risk Populations: Leverage established clinical collaborations to study Aspergillus infections in chronic lung disorders and neonatal candidemia. Investigate pathophysiology and epidemiology to develop evidence-based, personalised management strategies for populations with high morbidity and mortality.
programme is building critical capacity in low to middle income countries to improve patient outcomes and address the global burden of fungal disease. A £4.3 million investment in the FAILSAFE programme by GAMRIF is empowering 135 researchers worldwide to develop new diagnostics, treatments and vaccines to tackle the emergence of antifungal resistance.

The FAILSAFE network is the largest global community of researchers and clinicians in medical mycology with over 830 members spanning 82 countries. This initiative strengthens international collaboration and innovation to tackle one of the most urgent and under-recognised global health challenges, particularly in low- and middle-income countries.
Figure 6. Leveraged external research income by funder type, 2022–2025 (Clinical Mycology)
3.2 Diabetes
1. Introduction
Diabetes affects 4.8 million people in the UK and is a major cause of premature death, cardiovascular disease, kidney failure, and sight loss. It represents a major and growing cost to the UK, with estimates suggesting it costs the economy around £14 billion per year, including over £10 billion in direct NHS spending. Around 60% of this NHS cost is driven by potentially preventable complications, underlining the importance of earlier detection, and more targeted interventions.
For over 20 years, the University of Exeter and RDUH clinical academics have led global diabetes research, using precision genomics to redefine diabetes classification, identify more than 20 genetic subtypes, and deliver internationally adopted diagnostic tools for earlier, more accurate treatment.
Since the 1990s, research led by Professors Andrew Hattersley and Sian Ellard has transformed care for monogenic diabetes demonstrating that some infants can be treated with oral medication rather than insulin and, through Exeter’s EXCEED Centre of Excellence, continues to drive genomic discovery and precision medicine rapidly translated into NHS and international practice.
Three main research areas were specified in the application:
i. Diagnosis of all diabetes subtypes
ii. Optimisation of treatment for patients
iii. Identifying people for targeted diabetes prevention strategies.
Impact case studies submitted to NIHR as part of the original application:
i. Transforming the detection of genetic subtypes of early-onset diabetes throughout the world
ii. C-peptide testing improves the diagnosis and treatment of people with insulin-treated diabetes
iii. A type 1 diabetes genetic risk score improves diabetes classification
Methods: Discovery science and integration of existing and novel clinical, biomarker and genetic information, clinical testing and translation.
Objectives: Eight, all complete or on track.
2. Top 10 publications
1. Katte JM et al. (2025). Non-autoimmune insulindeficient diabetes in children and young adults in Africa. The Lancet Diabetes & Endocrinology.
2. Dennis JM et al. (2025). A five-drug class model to optimise prescribing in type 2 diabetes. The Lancet.
3. Luckett AM et al. (2025). Genetic risk contribution to phenotypic presentation in monogenic autoimmune diabetes. Diabetes.
4. Hu J et al. (2025). Genetic risk score discrimination between type 1 and type 2 diabetes in a Chinese population. Diabetologia.
5. Templeman EL et al. (2025). Multivariable prediction model for type 1 diabetes across screening studies. BMC Medicine.
6. Thomas NJ et al. (2026). Genetic risk-targeted autoantibody screening for presymptomatic type 1 diabetes in adults. The Lancet Diabetes & Endocrinology.
7. Brar G et al. (2024). Continuous glucose monitoring in elite athletes with type 1 diabetes. Journal of Physiology.
8. Shields BM et al. (2023). Patient stratification for optimal therapy in type 2 diabetes (TriMaster study). Nature Medicine.
9. Martin S et al. (2025). Undiagnosed G6PD deficiency and inequalities in type 2 diabetes diagnosis and complications. Diabetes Care.
10. Ferrat LA et al. (2025). Prediction of type 1 diabetes in autoantibody-positive individuals. Diabetologia.
3. Funding
From December 2022 to March 2025, Exeter BRC’s diabetes theme leveraged over £30 million in external income.
5. Success Stories

Jean Claude Njabou Katte was awarded a BRC Translational Fellowship in 2023 to study youngonset diabetes. This project embedded robust patient and public involvement across the UK and partner communities in Africa, using patient experience to guide research and ensure patient benefit. Supported by targeted training in grant writing and networking, his research was published in The Lancet Diabetes & Endocrinology (2025) and led to a Wellcome Trust Early Career Researcher Fellowship worth over £800,000.
Researchers within the Theme have also shown that G6PD deficiency can distort HbA1c results, delaying diagnosis and increasing the risk of complications for Black and South Asian men in the UK, revealing a previously unrecognised health inequality.

4. Forward Look
Establishing national Infrastructure: South West Secure Data Environment, University of Exeter and BRC researchers have been working to develop the blueprint for a national diabetes dataset to be tested and scaled throughout 2026.
A renewed theme would build on our strengths and tackle key gaps in understanding, diagnosis, and treatment.
Key areas for the future
Type 2 Diabetes Treatment: Refine treatment selection models incorporating newer therapies, extend application to young-onset and ethnically diverse populations, and test the added value of genetic risk scores.
Type 2 Diabetes Diagnosis: Develop decisionsupport tools integrating age, sex, ethnicity, and genetic variants to reduce over- and under-diagnosis, including recruiting the Black Health Legacy cohort to improve diagnostic equity.
Improving Diagnosis of Diabetes Subtypes: Develop classification models and biomarker-based tests and implement CE/UKCA-marked tools in clinical practice.
Novel Insights into Type 1 Diabetes Pathophysiology: Investigate small, beta-cell-rich pancreatic structures absent in T1D and understand their molecular and functional roles.
Screening to identify pre-clinical Type 1 Diabetes: Development of screening strategies, informing how to identify adults who would benefit from T1D prevention immunotherapy drugs.

Leadership within the Team is exemplified by Andrew Hattersley, recipient of the European Association for the Study of Diabetes Claude Bernard Prize. Andrew also co-hosts the podcast series One in Six Billion alongside Maggie Shepherd (BRC Senior Investigator Fellow, Nurse). The series aims to inform the general public about genetics in diabetes, with a particular focus on rare and unusual genetic forms of the condition. To date, the podcast has achieved over 15,000 downloads across 86 countries and produced 52 episodes over two years, featuring 70 expert guests.

Figure 7. Leveraged external research income by funder type, 2022–2025 (Diabetes)
3.3. Genomics and Genetics
1. Introduction
Genetics and genomics research is internationally recognised for transforming diagnosis and care across rare and common diseases. Rare genetic conditions affect around 7% of the population, with a disproportionate burden in deprived and minority ethnic communities and cost the NHS an estimated £300 million annually. Diagnostic delays often exceed seven years, and accurate genetic diagnosis enables targeted treatment, prevents disease progression and is consistently described by families as transformative. Beyond rare disease, Exeter’s research is advancing understanding of the genetic drivers of multimorbidity and multiple long-term conditions, such as obesity that underpin many chronic diseases, supporting earlier diagnosis, better stratification and more personalised care pathways.
Three main research areas were specified in the application:
i. Understanding genomic mechanisms in undiagnosed rare disease
ii. Population-scale genetics to refine penetrance and pathogenicity
iii. Personalised and mechanistic insights for common disease
Impact case studies submitted to NIHR as part of the original application:
i. Discovery of novel genes and disease mechanisms in rare disease underpinning new treatments and diagnostic tests
ii. Precision treatment in patients with inflammatory bowel disease
iii. SNP-chips perform poorly for rare variants
Methods: Integration of advanced genomic technologies, unique patient resources, populationbased studies, and translational clinical approaches to accelerate diagnosis, improve treatment, and inform ethical practice and public engagement.
Objectives: Ten, all complete or on track
2. Top 10 publications
1. Murrin O et al. (2025). Genetics contribution to multimorbidity: systematic analysis with primary care comparisons. eBioMedicine.
2. Copeland H et al. (2024). Outcomes following a genetic diagnosis in children with severe developmental disorders. https://www.nejm.org/ doi/10.1056/NEJMoa2209046.
3. Fasham J et al. (2026). 16p13.3 triplications causing a neurodegenerative disorder with ataxia. American Journal of Human Genetics.
4. De Franco E et al. (2023). Primate-specific ZNF808 is essential for pancreatic development. Nature Genetics.
5. Loginovic P et al. (2024). Genetic risk score prediction of multiple sclerosis following optic neuritis. Nature Communications.
6. Lucas MR et al. (2024). HFE genotypes, haemochromatosis diagnosis and clinical outcomes at age 80. BMJ Open.
7. Hawkes G et al. (2025). Whole-genome sequencing identifies rare regulatory variants influencing circulating protein levels. Nature Genetics.
8. Wright CF et al. (2024). Estimating penetrance of monogenic disease variants in population cohorts. Nature Genetics.
9. Kingdom R et al. (2024). Genetic modifiers of rare variants in developmental disorder loci. Nature Genetics.
10. Stankovic S et al. (2024). Genetic links between ovarian ageing, cancer risk and mutation rates. Nature.

3. Funding
From December 2022 to March 2025, Exeter BRC’s genetics and genomics theme leveraged over £29.5 million in external income.
4. Forward Look
A renewed theme would address key gaps in understanding, diagnosis, and treatment, aligning with the Government’s ambition to pivot “from sickness to prevention” using predictive genomics (NHS 10-year plan, 2025) and ensuring Exeter remains a national hub for genomic medicine, delivering research, implementation, and patient benefit.
Key areas for the future
Rapid Genomic Diagnosis: Expand genome sequencing for critically ill children and adults with rare diseases. Integrate novel sequencing technologies and multiomic analyses into routine care to improve diagnostic yield, patient outcomes, and equitable access.
Discovery of New Genetic Mechanisms: Identify previously unrecognised genetic causes and modifiers of disease. Population-scale and prospective studies will refine penetrance and pathogenicity estimates, enabling responsible return of clinically actionable results.
5. Success Stories

The BRC supported a major public dialogue in 2024, “Rare Disease Genomic Testing: How Do We Make Access Equitable and Timely?”, engaging 226 participants from 74 organisations and embedding diverse voices and lived experience. The dialogue improved understanding, influenced perspectives, and highlighted practical strategies to support more equitable and timely access to genomic testing, demonstrating the BRC’s impact on awareness, policy thinking, and future service delivery.

Senisca is an award-winning spin-out developing RNA-based senotherapeutics designed to reprogramme senescent cells and reverse key mechanisms of cellular ageing, a fundamental driver of conditions such as lung fibrosis and osteoarthritis. Working with the rehabilitation
Translation into Clinical Practice: Develop professional guidelines, decision-support tools, and validated pipelines to embed genomics in the NHS. Collaborate with commercial partners and train NHS staff to ensure discoveries reach patients safely and efficiently.
Prevention and Early Detection: Use predictive genomics to improve health, focusing on underserved populations and conditions such as inherited cancer risk, women’s health, and metabolic disorders. Integrate genomic risk into primary care to enable early intervention and disease prevention.
theme to design clinical proof of concept studies, Senisca has progressed from laboratory discovery to commercial translation, securing major industry partnerships including a collaboration with L’Oréal to advance longevity research.
A landmark NIHR Exeter Biomedical Research Centre-supported study (the GEMINI project) analysed genetic and clinical data from more than three million people, uncovering genetic overlaps across 72 long-term health conditions and revealing new opportunities to prevent or treat multimorbidity. This project embedded strong PPIE throughout to ensure the patient voice was represented, with the public collaborators influencing the comorbidities that were identified for investigation. By identifying shared genetic links and potential targets for repurposing drugs or lifestyle interventions, the research paves the way for more personalised approaches to managing multiple long-term conditions that affect millions of people and drive high NHS costs.
3.4 Neurodegeneration
1. Introduction
Neurodegenerative disorders place a huge burden on the UK, with over 850,000 people living with dementia, 3-5m with early cognitive impairment, and 140,000 with Parkinson’s Disease, costing the economy over £26bn annually. At Exeter, researchers are tackling these challenges through interdisciplinary programmes that span basic science, clinical studies, and innovative trials. Exeter scientists are using advanced neuroimaging, genomic, and stem-cell approaches to understand the causes and progression of brain disease, and to identify new targets for early diagnosis and treatment.
Three main research areas were specified in the application:
i. Drug discovery and repurposing
ii. Neuropsychiatric symptoms and dementia risk
iii. Biomarkers and patient stratification
Impact case studies submitted to NIHR as part of the original application:
i. Understanding and treating neuropsychiatric symptoms in Parkinson’s disease and Alzheimer’s disease
ii. Discovery to Clinical Trial Pipeline for the treatment of neurodegenerative disease
iii. Digital Brain Health as a platform for translational research
Methods: Discovery and integration of existing and novel biomarkers and genomic information, patient stratification, and precision medicine translation.
Objectives: Five, all complete or on track.
2. Top 10 publications
1. Huber H et al. (In press). Capillary blood biomarkers (p-tau217, NfL, GFAP) for detection of Alzheimer’s disease pathology (DROP-AD). Nature Medicine.
2. Nørgaard CH et al. (2022). GLP-1 receptor agonists and incidence of dementia: pooled RCT and registry data. Alzheimer’s & Dementia.
3. Edison P et al. (2025). Liraglutide in mild to moderate Alzheimer’s disease: phase 2b clinical trial. Nature Medicine.
4. Sabbagh MN et al. (2025). Repurposing GLP-1 receptor agonists for neurodegenerative disorders. Nature Aging.
5. Ballard C et al. (2020). Drug repositioning and repurposing for Alzheimer disease. Nature Reviews Neurology.
6. Tariot PN et al. (2021). Pimavanserin trial in dementia-related psychosis. New England Journal of Medicine.
7. Cummings J et al. (2024). Pharmacologic management of neuropsychiatric syndromes in neurodegenerative disorders. JAMA Neurology.
8. Guan DX et al. (2024). Cognitive and behavioural reserve: evidence from the CAN-PROTECT study. Alzheimer’s & Dementia.
9. Ismail Z et al. (2023). Biomarker detection of Alzheimer’s disease in mild cognitive impairment. Molecular Neurodegeneration.
10. Creese B et al. (2023). Late-life psychotic symptoms and incident cognitive impairment modified by genetic risk. Alzheimer’s & Dementia.
3. Funding
From December 2022 to March 2025, Exeter BRC’s Neurodegeneration theme leveraged over £43 million in external income.
4. Forward Look
A renewed theme would build on our strong platform in trials, genomics, biomarkers, and precision medicine to accelerate early detection and disease-modifying interventions.
Key areas for the future
Drug Repurposing and Novel Therapies: Complete ongoing phase 2 trials of key identified candidates (fasudil and phenserine) and progress the strongest new candidates into late-phase testing. Expand precision repurposing trials across Alzheimer’s Disease (AD), Parkinson’s Disease (PD), Lewy Body Dementia (LBD), and Amyotrophic Lateral Sclerosis (ALS). We have also completed an RCT of pimavanserin for dementia related psychosis, have innovated clinical trial design in this area with novel approaches to reducing placebo response and data analysis and are currently working with commercial partners on 4 new trials.
Precision Medicine and Stratified Trials: Scale genomic-risk cohorts (E4 homozygotes, GBA carriers) and integrate data from the UK Human Functional Genomics Initiative to refine stratification and drive adaptive platform trials. Take forward targeted studies in GBA carriers, individuals with pre-psychosis and individuals with REM sleep behaviour disorder.
Neuropsychiatric Risk and Early Intervention: Prioritise interventions for pre-psychosis, sleep disturbance, and MBI as key early dementia risk states. Build on effective non-pharmacological approaches demonstrated in Long COVID, MCI and neuropsychiatric symptom trials, including experimental medicine studies to better understand the mechanisms driving benefit.
Next-Generation Biomarkers and Diagnostics: Advance capillary p-tau217 and cfDNA assays toward clinical use to transform early diagnosis and trial recruitment. Expand patient-derived cell and organoid platforms to accelerate therapeutic screening.
5. Success Stories The team leads the PROTECT study, one of the world’s largest remote ageing and dementia cohorts. PROTECT has recruited over 65,000 participants to clinical trials, supported more than 150 academic and industry collaborations, generated over 100 peer-reviewed publications, and delivered in excess of £25 million in research and commercial income. The programme has pioneered remote clinical trial delivery, enabled the generation of large-scale genomic datasets, and identified early social and neuropsychiatric risk markers associated with adverse mental health outcomes and progressive cognitive decline.
Internationally, the team is recognised for its leadership in drug repurposing for dementia, particularly in relation to GLP-1 receptor agonists. This includes a Delphi consensus published in Nature Reviews Neurology identifying GLP-1 analogues as high-priority repurposing candidates. The programme culminated in a phase 2 clinical trial of liraglutide, published in Nature Medicine (2025), which demonstrated significant benefit in people with Alzheimer’s disease and co-existing vascular pathology. These findings highlight a major opportunity for phase 3 trials in an area of substantial unmet clinical need.

Researchers within the Theme have developed a novel capillary blood test for Alzheimer’s disease, with recent work published in Nature Medicine demonstrating excellent concordance between capillary p-tau217, venous blood, and cerebrospinal fluid biomarkers. The study also showed strong agreement between selfadministered and nurse-administered sampling, highlighting the feasibility of home-based testing. This approach has significant potential to transform diagnostic pathways and to streamline recruitment and screening for Alzheimer’s disease clinical trials.

Figure 9. Leveraged external research income by funder type, 2022–2025 (Neurodegeneration)
3.5 Rehabilitation
1. Introduction
The Rehabilitation theme focuses on improving mobility, reducing falls and maintaining independence in older people. Although a relatively new research area at Exeter, targeted investment in 2019 built on existing academic expertise and world-class facilities within the university’s internationally leading Sports Science department.
Exeter’s long history of surgical innovation, most notably the Exeter Hip Stem, has been strengthened through a renewed focus on musculoskeletal research. This has invigorated Exeter’s role in rehabilitation science, linking surgical innovation with recovery, function and long-term independence in later life.
Three main research areas were specified in the application:
i. Falls and movement quality in later life
ii. Predictive algorithms for functional decline
iii. Improving orthopaedic surgery outcomes for frail older people
iv. Developing and evaluating assistive and intelligent devices.
Impact case studies submitted to NIHR as part of the original application:
i. Cement and instrumentation for joint replacement
ii. Delivering the rewards of NIHR investments in translational rehabilitation research
iii. Quiet eye training (QET) to improve precision in motor performance
Methods: Experimental medicine paradigm combining clinical testing, motion analysis, predictive modelling, and translational evaluation of novel surgical and assistive interventions.
Objectives: Six, all complete or on track.
2. Top 10 publications
1. Rosenblum U et al. (2025). Anxiety-related attentional characteristics and freezing of gait in Parkinson’s disease. Journal of Parkinson’s Disease.
2. Allan L et al. (2025). Maintaining independence in people with dementia following a fall (MAINTAIN trial). Age and Ageing.
3. Beard D et al. (2022). Rehabilitation versus surgical reconstruction for ACL injury (ACL SNNAP trial). The Lancet.
4. Greenwood DC et al. (2024). Symptom fluctuation triggers in people living with long COVID. The Lancet Regional Health – Europe.
5. Medina S & Hughes SW (2025). Virtual reality immersion reduces mechanical secondary hyperalgesia. Pain.
6. O’Leary M et al. (2025). Polyphenol supplementation effects on cognition and health in older adults at risk of decline. Food & Function.
7. Matthews AH et al. (2025). Travel distance and perioperative outcomes following revision knee replacement. BMJ Open.
8. Sansum KM et al. (2025). Physical activity, sedentary behaviour and cardiovascular health in children (ALSPAC study). Scientific Reports.
9. Mayo NE et al. (2024). Real-time auditory feedback to improve gait in Parkinson’s disease. Pilot and Feasibility Studies.
10. Tomkinson GR et al. (2025). International norms for adult handgrip strength: systematic review. Journal of Sport and Health Science.
3. Funding
From December 2022 to March 2025, Exeter BRC’s rehabilitation theme leveraged over £22.5 million in external income.

DigiTherapix, is a prospective spin-out led which delivers modular digital rehabilitation tools for clinical, occupational and home settings. Underpinned by protected intellectual property, the platform has attracted strong international interest from insurers, healthcare providers and investors in regions including China, Saudi Arabia and Canada.
4. Forward Look
The renewed rehabilitation theme will build on its strong NIHR-aligned momentum, positioning the South West as a national hub for innovation.
Key areas for the future
National Community of Rehabilitation Research: Expand by integrating clinical, allied health, engineering, and patient expertise. Advance exergaming and gait-training trials, complete surgical trials for muscle preservation, and validate predictive tools for falls and mobility decline across neurodegenerative, developmental, and musculoskeletal conditions.
Technology: Accelerate development of digital clinical outcome assessments, digital biomarkers, telerehabilitation, and virtual interventions. Optimise facilities, including VSim, and integrate NHS mobile units and the East Devon Community Diagnostic Centre to support innovation, cohort development, and precision research.
Prevention: Deliver primary, secondary, and tertiary interventions using existing datasets (BIOBANK, SEISMIC, PROTECT, EPIC, Plymouth Living Lab) and workplace initiatives, while leveraging engineering, mathematics, and NIHR training to build health technology literacy across NHS, industry, and academia.
Alongside commercial innovation, NIHR and BRC investment has driven translation into routine NHS care. The BOOST group physiotherapy programme for spinal stenosis has improved walking ability, reduced disability and shown strong cost-effectiveness. Following refinement and implementation work, a free digital training package now enables NHS clinicians to deliver the intervention at scale, resulting in sustained improvements in pain, function and safer medication use for older people.

Figure 10. Leveraged external research income by funder type, 2022–2025 (Rehabilitation)
5. Success Stories
4. Performance of Core Functions
4.1 Academic Career Development
Academic career development, encompassing both academic and clinical academic career pathways, is a core, well-governed function of the NIHR Exeter Biomedical Research Centre and underpins the Centre’s ability to deliver the next generation of leaders in clinically impactful research. The BRC provides structured, targeted support across the full academic pipeline, aligned with NIHR Academy principles and integrated with NHS and University of Exeter career pathways.
Researchers are supported through clearly defined fellowship schemes, doctoral training and early-career opportunities, embedded within multidisciplinary teams across the BRC’s core and emerging themes. All programmes are supported by formal mentoring, access to specialist methodological and experimental medical and clinical expertise, and strong patient and public involvement.
Fellowship Programmes (See Appendix 11 for details)
Senior Investigator & Consultant Researcher Fellowships (12 in total; 5-year tenure ~0.2 FTE)
Provide protected time and infrastructure support for outstanding NHS senior clinical academics to undertake key leadership roles within the BRC and/ or develop major translational research programmes. Fellows are expected to secure substantial external funding, develop international collaborations, deliver high-impact translational research and receive nationally competitive early-career awards.
Mid-Career Fellowships (11 in total; 2-year tenure ~0.5FTE)
Support NHS clinical academics at a critical transition point to research independence. Outcomes include successful external grant awards, leadership of regional and national collaborations, policy influence, and delivery of clinically relevant research outputs.
Translational Fellowships (11 in total; 2-year tenure ~1 FTE)
Translational Fellowships support early- to midcareer translational scientists to progress towards independence while working closely with NHS and industry partners. Fellows are expected to secure substantial external funding, develop international collaborations, deliver high-impact translational research and receive nationally competitive early-career awards.
Pre-application awardees (9 in total, 6 to 16 months tenure, ~0.2 FTE)
Designed to buy out clinical time and provide a training budget to help NHS clinicians and Allied Health Professionals to develop applications for NIHR programmes from pre-doctoral through to Advanced Fellowships and other grant applications schemes.
Doctoral
Training and Development
PhD Studentships (21 in total)
We expanded the original BRC funded cohort of 10 students with university match funding and external philanthropic support. Some students benefit from interdisciplinary supervisory teams spanning university and NHS clinical, methodological and laboratory expertise.
The BRC contributes to the wider doctoral research environment within the Faculty of Health and Life Sciences, engaging with over 230 PhD students through open PPIE training and support activities, seminar programmes, access to theme discretionary funding and opportunities to connect with BRC themes and researchers.
Internships, Professional Training Years and Work Experience (12, 11 & 13 respectively, to date)
These include full-time summer internships and part-time placements for medical and nursing undergraduates, professional training years for science-based undergraduates and regional widening-participation schemes delivered with NHS and university partners. Opportunities are mapped across all five themes and expose participants to a broad range of translational research careers.
The Exeter BRC supports training across the career pipeline. To date, we have delivered £19,000 and
50+hours of bespoke training events including grant writing workshops, presentation and interview skills, entrepreneurship, grant workshops. We link our community to training opportunities for technical and academic careers. We have worked with University of Plymouth and other partners to develop a Research Skilled Workforce strategy, including conferences, comprehensive online training materials/guidance for NHS staff interested in incorporating research into their practice.
Outcomes for fellowships Outcomes for fellowships, to date, are shown in Appendix 11.
Table 2. Capacity building and training activity across NIHR Exeter BRC themes.
Theme-Level examples
5 active patents
Growth & Collaboration
7
2 £6.8m
1 86 spinouts/ licences in development commercial licences industry research income for 2024/2025 spin-out created industry partnerships
Diabetes: Licencing deals in development for a platform described by Diabetes UK as “the most significant advance in Type 2 Diabetes care in over a decade.”
Genetics/Genomics: We host the co-ordinating centre for the £28.5m UKRI Human Functional Genomics Initiative, engaging directly with senior pharmaceutical partners and providing ringfenced funding for academic–industry collaboration.
Clinical Mycology: The CMM hosted its first academic Industry Partnerships Summit in November 2025, from which it has developed some very positive advances with industry partners, generating several significant proposals for contract research and further development opportunities.
Rehabilitation: DigiTherapix, our first BRC spinout company, is accelerating quickly, gaining healthcare and investor interest, winning awards, and has now been accepted on to a business incubator.
Partnership Development & Pipeline Growth
We have established structured partnership models with pharmaceutical R&D pipelines, with active collaboration and application pipelines now established with Daiichi Sankyo, and similar models under development with AstraZeneca and Novo Nordisk
Strengthening the Ecosystem
The Centre for Life Science Technologies (University of Exeter - Centre for Life Science Technologies | LinkedIn) is rapidly broadening our commercial footprint in sequencing and bioimaging —and provides further infrastructure for sustained industry collaboration. Access to advanced clinical trial infrastructure, digital biomarkers, and rich longitudinal datasets continues to be a major attractor for industry. Commercial Successes
Neurodegeneration: PROTECT (30,000+ participants) has now supported multiple decentralised commercial trials across pharma, biotech, and nutrition. This will be the next spinout company from the Exeter BRC.
4.2 Commercialisation and Industry Engagement
Exeter BRC has built commercial momentum, expanding its industry partnerships, strengthening capacity, and accelerating translation across all themes. By aligning NHS partners, the university, and industry within a coordinated NIHR Exeter BRC framework, we have established a scalable model that can move ideas from early-stage discovery to deployable solutions.
Doubling of research industry income
We are starting from a relatively low base, in a region of the country that has only limited commercial activity. Nevertheless, two verified sources of income return show we have been able to double commercial income since the BRC inception (Higher Education Business and Community Interaction Survey in Appendix 13), and through data that was collected by the University Technology Transfer Office (Exeter Innovation). We have strong examples of how, when working with industry, we have been able to deliver substantial benefits in health and wealth generation.
Working together to improve our commercial income
We are creating new structures and support systems for BRC academics and clinicians to increase their skill in leveraging commercial research income. In the University we have appointed two senior commercial faculty leadership roles, two Entrepreneurs in Residence, four Professors in Practice and 3 dedicated leadership roles in Business Development and Commercialisation in university departments that face into the BRC.
The RDUH and University work in commercial clinical trials, with an established South West Commercial Research Group running in several of the Trusts we are working with, and notable income streams from Vaccine Clinical Trials, Target Validation, Genetics and Genomics/Biomarker development income streams. We host strategic grants with Stryker Ltd, to continue important research in development of cements, protheses and the like for revision joint replacement.

Figure 11. Driving Innovation: Exeter BRCs commercialisation impact
4.3 Patient & Public Involvement and Engagement
Our PPIE strategy is shaped by community and PPIE groups and other stakeholders and sets out a clear framework for embedding meaningful involvement. The strategy focuses on understanding needs, strengthening support for researchers, widening inclusion and working collaboratively to improve reach and impact. In the first half of the BRC award, activity has concentrated on embedding PPIE within core processes and building strong foundations for inclusive involvement. We actively build and maintain partnerships across the NIHR infrastructure and other organisations, sharing best practices and contributing to a collective advancement of PPIE in research.
Public contributors are embedded across BRC governance (including two contributors who sit on our Management Board, Catherine and Rebeka), funding and delivery. They review grant applications, sit on recruitment panels and provide input through representation on the Management Board, ensuring that research priorities, plans and decisions are informed by lived experience. Our PPIE programme is also shaped by ongoing feedback from a core PPIE group and wider partners, including gathering feedback on strategic directions and operational issues. In addition to our core group of people from across the South West, we regularly work with other PPIE groups from across the NHS, local NIHR infrastructure and university to provide specialist input (to match with
thematic areas and ensure regional coverage). We invite people at engagement events to sign up to our mailing list to hear about ad hoc opportunities for involvement. Targeted outreach in rural and coastal areas, alongside researcher-led public engagement activities, has broadened awareness of involvement opportunities and brought new voices into research.
Reaching underserved communities across the South West is a key priority. Many public contributors involved through the BRC had no previous experience of research, offering fresh perspectives and strengthening relevance.
Researchers are supported through tailored advice, co-created training, early-stage engagement opportunities and direct input into funding applications, which we adapt, add to and improve based on researcher feedback.
Key Activities: The impact of PPIE across the BRC shows how public contributors work in partnership with researchers to shape funding applications, recruitment processes, and research design, strengthening the quality and relevance of BRC-supported studies. It also reflects the PPIE team’s role in building researcher capability and extending engagement across the South West through accessible PPIE cafés and events, supporting meaningful dialogue with patients and the public across Devon, Somerset, and Cornwall.
4.4 Research Inclusion
Our Research Inclusion strategy is structured around three pillars: targeting underrepresented communities, embedding inclusive culture across the workforce and strengthening data collection to support evidence-led practice.
Targeting underrepresented communities to participate/support research
The South West peninsula has significant areas of rural and coastal deprivation, and these communities are often long distances from our main research centres. We have focused outreach activity to rural and county shows, on food banks in North Devon and migrant communities in Exeter and Plymouth. We have established dedicated research facilities in Barnstaple, which is the most remote NHS Trust in the UK, and a network of mobile research vans which will bring research to remote communities across Devon and Cornwall.
There are only small sized ethnic communities in the South West, which brings many challenges (particularly isolation). We have worked in several ways, within our region and beyond to ensure that our research samples have the diversity they need (for example in Genetics and Genomics). An example is our support of a project which resulted in a Wellcome Discovery Grant working with the Caribbean & African Health Network to facilitate community engagement and support recruitment of 2,500 participants from Black British, African and Caribbean communities with type 2 diabetes.
We are working at a national level to promote best practice, for example, working with the NHS Ethnic Minorities Network to review recruitment, research and other work across NIHR infrastructures. Professor G.J. Melendez-Torres (UoE) has been appointed as Dean for Research Inclusion at the NIHR.
Enabling and helping NHS and university researchers to improve research inclusion
We have created tools for researchers to develop their skills with an “inclusive by design” approach. An example is the Event Toolkit, which helps think through event planning in an inclusive way (PPIE, academic and public events). It encourages best practice from planning to delivery to collating feedback.
Research inclusion in research commissioning
As much of our funding is distributed in small internal competitions, we have a substantial opportunity to ensure research inclusion is addressed in all applications. Applicants have to complete a dedicated section on inclusion. The panel deciding awards reviews all sections and includes at least 2 PPIE panel members from a range of communities.
Recruitment into BRC funded positions and specific strategies to engage people into careers in Translational Medical research
We have a dedicated Equality, Diversity and Inclusion group (details in Appendix 5.1), who have reviewed our recruitment documentation, to ensure they meet best practice standards across our partner organisations and the NIHR. Recruitment criteria have been revised to ensure that experience and expertise were given the same weighting as qualification, which has broadened the pool of applicants. We have run broadening participation schemes for schools and colleges across our region, as well as targeted opportunities for University students.
Working with the university and NHS to frame equality, diversity and inclusion
Both the University and NHS Trusts work proactively to develop and promote EDI best practice. We have leveraged this opportunity. For example, the University of Exeter recently secured the Race Equality Charter and has participated in the 100 Black Female Professors scheme. Two of these 6 aspiring professors have been appointed in BRC themes. They receive bespoke mentoring from senior members of the BRC, and both have now secured tenured senior academic positions. We have recruited with the Health Data Research UK Black Internship Programme for Data Science Interns.
Collecting EDI metrics to monitor our progress Inclusion metrics are routinely collected across events, training and awards, enabling consistent monitoring and comparison1. Total Research Inclusion expenditure in the last financial year was £220,950, supporting targeted recruitment, internships, work experience, EDI events, PPIE activity and dedicated staff time.
4.5 Data Science
University of Exeter has substantial strength in Data Science, and this discipline features in all our research themes. We have benefitted from exceptional computing infrastructure through our partnership with the GW4 Universities, the Centre for Mathematics in Health Care, and university investment in research software engineers. This year we have appointed a BRC Academic Lead for Data Science, Professor Yinghui Wei, who, in partnership with BRC Senior Investigator Fellow, Nick Kennedy, Chief Research Information Officer at Royal Devon University Hospitals NHS Trust, supports the national BRC Informatics group. We have partnered with the NHS South West Secure Data Environment (SWSDE) requiring BRC researchers to make suitable research generated datasets available to both the SDE and the Health Data Research UK (HDRUK) gateway. The partnership allows the BRC to apply to use routinely collected health data safely and responsibly to understand population need, identify risk earlier and evaluate interventions across diverse communities. This is particularly important in areas of socioeconomic deprivation, where digital exclusion
and structural disadvantage can increase poor health outcomes across children and young people, working-age adults and older populations.
Together, the BRC and SWSDE are bringing together data science expertise from across the peninsula to co-develop novel, linked data assets that can be made more accessible to researchers through robust SDE governance frameworks. This strengthens the quality, reproducibility and real-world relevance of our research, while reinforcing public trust in how health data are used for public benefit.
4.6 Communications
In the last twelve months, we have issued in excess of 40 press releases featuring BRC funded and supported work and the BRC has featured in 62 items of regional and national media coverage. Social media allows us to reach a wider audience, with insights showing a rise of 150%, to 22,858 impressions through LinkedIn over the last 3 months.
The BRC communications office has led on ensuring impact stories are created in the right way and delivered in a timely manner to the NIHR.
4.7 Key Strengths and Areas for Improvement
This report provides a description of the Exeter NIHR BRC, and additional information to contextualise our regional offering to the broader BRC family.
We have focused on formal objectives agreed between ourselves and the NIHR, but these do not capture the full breadth of the way in which we work, and the impact of our work. We will present more detail at the External Advisory Board.
We believe we have gained strong momentum and good delivery across the first funding period. The themes are established and are working productively, in terms of our work with NHS partners, we have accelerated well but recognise that progress varies across partners. Our BRC includes six NHS trusts serving rural, coastal and urban populations, and we enable place-based research that directly addresses health inequalities while generating evidence of national relevance and scalability. Collectively, the Trusts serve some of the most socioeconomically deprived areas in the UK. For some of our Trust collaborators, the BRC has enabled our first joint venture into translational medical research. For others, the BRC has consolidated and expanded activity. For all, the BRC has allowed access to important capital development funding alongside the activities described in the report.
We have developed emerging themes. University and NHS investment has enabled us to make new appointments, opening up the possibility of enhanced or new thematic areas. These will be presented at the Advisory Board. We have improved our Data Science infrastructure and continue to develop in this nationally important area.
We are fortunate in the South West to have several large NIHR infrastructure grants, and we work in very close collaboration with the Peninsula Applied Research Collaboration (ARC) and the HealthTech Research Centre (HRC). Our Clinical Research Facility in Exeter received substantially reduced funding, which has been a significant barrier to expanding clinical trials and similar research.
While the BRC has established a strong foundation for commercial engagement and industry collaboration, there is a clear need to further strengthen and embed commercialisation activity across the research portfolio. In particular, improving the early identification of commercially relevant opportunities and strengthening alignment with NHS adoption and implementation pathways. While the South West offers a strong environment for placebased and inequality-focused research, its geography also presents structural challenges. Distance from major industry hubs and cities can reduce informal access to commercial partners and innovation networks, potentially slowing commercialisation and scale-up. This reinforces the need for strong national partnerships and digital capability.
The BRC operates as a distributed partnership rather than from a single physical centre and it can sometimes feel fragmented. Not everyone identifies strongly with it, and the boundaries of the network are not always clear, particularly at its edges. This can mean that some excellent people and activity are missed simply because they are not visible or well-connected into the Centre. One such example is our publication numbers. In principle, we could have reported up to 2,292 publications if all outputs had correctly acknowledged NIHR funding and been reported as required. Addressing this has taken time, as it required changing established practices around both acknowledgement and reporting. While progress has been made, this remains an area of ongoing improvement. As we go forward, we will spend more time in developing cohesion and network alliance.
Figure 13. Average Scores for Accessibility and Inclusivity at NIHR Exeter BRC Events in 2025/2026